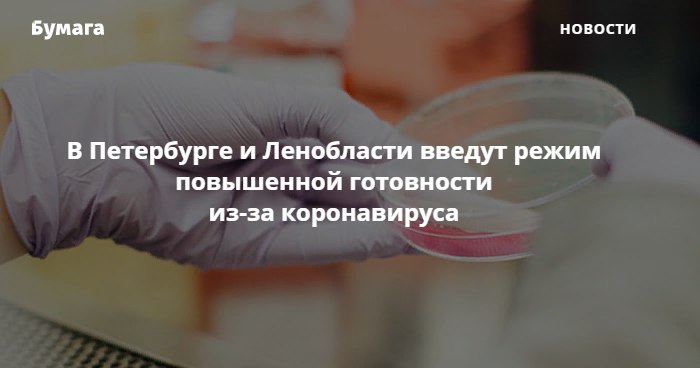

Вчера выпустили интервью с петербургским гематологом Борисом Афанасьевым, который провел первую в СССР трансплантацию костного мозга ребенку. Если пропустили, прочитайте, как в Петербурге появились НИИ детской онкологии, фонд AdVita и база потенциальных доноров: https://clc.to/kTlwNQ.
Приятной пятницы!